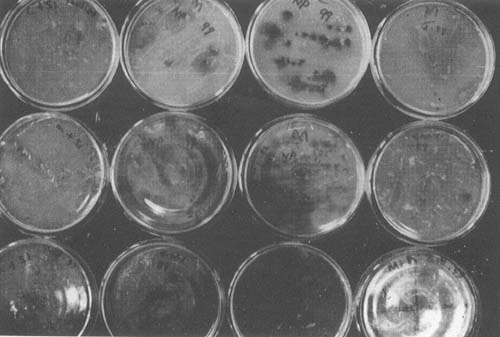
Plate V

by
C. M. James
Consultant
In a hatchery system, production of live natural foods is of paramount importance, since the natural larval foods consist of highly diverse plankton populations, which crustaceans, molluscs and fish larvae consume during their different larval stages. The culture of live food organisms such as unicellular green algae, diatoms, rotifers, copepods, cladocerans and Artemia is an integral part of aquaculture. One of the basic problems in aquaculture is to supply sufficient live food of the best quality at the lowest cost, upon demand. The production of live food organisms is amenable to a technological approach, in which the food quality can be manipulated and additives may be used to improve utilization and efficiency, and to increase growth rates and thereby decrease production costs.
The unreliability of most live food production systems continues to pose a problem for many aquaculture operations in which unicellular algae and zooplankton are the primary food sources. At present, applied research is given priority over basic research in most aquaculture centres in order to meet the requirement of practical diets for aquaculture purposes.
The present consultancy programme on live food production at the Fisheries Research Institute at Glugor, Penang under the auspices of the United Nations Development Programme and the Food and Agricultural Organization was aimed at meeting the following objectives:
to demonstrate the culture of unicellular algae, marine yeast, rotifers, copepods and adult Artemia as live foods for larval shrimp and fish,
to provide advice on the modification of existing culture facilities and the construction of new ones (if needed), and
to provide training for national staff through the practice of culture operations.
| 1 September, 1982: | Arrival in Penang, Malaysia. Discussions with the Director and staff of the Fisheries Research Institute at Glugor, Penang. |
| 2–8 September, 1982: | Phytoplankton culture (unicellular algae): |
| a. Isolation and selection of local species. | |
| b. Maintenance of stock culture. | |
| c. Production trials. | |
| 9–22 September, 1982: | 1. Marine yeast culture |
a. Inoculation and maintenance of stock cultures. | |
b. Production trials.* | |
| 2. Rotifer culture | |
a. Separation of local species for taxanomic studies. | |
b. Experiments on different feed combinations. | |
c. Production trials. | |
| 2. Artemia culture | |
a. Demonstration of decapsulation technique. | |
b. Fabrication of experimental culture facilities. | |
| 23–27 September, 1982: | Copepod culture |
| a. Isolation of suitable copepods. | |
| b. Culture trials. | |
| 28 September, 1982: | Departure from Penang and arrival at Johar Bahru. Visit to the Brackish Water Aquaculture Centre, FAO/UNDP. |
| 29 September, 1982: | Discussions with Mr Harry L. Cook, Team Leader, Coastal Aquaculture Programme, UNDP/FAO, Malaysia. |
| 30 September, 1982: | Departure from Johar Bahru for Kuwait. |
* Subject to the availability of culture facilities.
The continuous production of unicellular algae has an essential supporting role in the rearing and maintenance of many marine invertebrates, at both laboratory and commercial scales. Algae provide one of the few practical means of mass feeding aquatic filter feeders, and therefore algal cultures must be maintained in the same laboratory or nearby.
3.1 STATUS AND CONSTRAINTS
The usual technique for algae has been to employ a multistep back-up system, whereby small scale cultures are grown and used as inocula for larger scale cultures, which in turn are used as inocula for still larger ones; the final culture unit being a large indoor or out-door tank. The culture of unicellular algae and diatoms such as Chlorella virginica, Tetraselmis chuii and Chaetoceros calcitrans at the Fisheries Research Institute at Glugor was being hampered by the following biological and technical constraints:
It had not been possible to keep the algal species in pure culture due to contamination by other species.
The frequent failure of cultures was due to the seasonal changes in salinity, temperature and photoperiod and also due to lack of suitable micro-nutrients.
The cell density of the cultures was too low.
The technology and facilities required for the isolation of local species for aquaculture purposes were not available.
3.2 DEMONSTRATION AND ACCOMPLISHMENTS
The research staff at the Fisheries Research Institute had recognised necessity of refining the culture of algal species and isolating suitable species for aquaculture purposes. The staff involved were: Ms. Faazaz Mr. Ng
To facilitate the process of isolation and the maintenance of stock cultures, locally available materials were utilized for the fabrication of an incubation unit (Plate I). The use of micro-capillary pipettes, agar plating techniques and dilution methods for the isolation of unicellular algae were demonstrated. The micro-capillary pipettes were used to isolate single algal cells in a sterile medium and by repeating this procedure many times the ratio of bacterial to algal cells was gradually reduced until individual cells of the desired species could be transferred to a sterile medium and allowed to multiply (Plates II & III) Agar plating (Plates IV & V) was carried out by using 1.5% bactoagar in seawater along with Miquel's medium (Table 1) or Conway medium (Table 2).
Rapid exhaustion and subsequent non-availability of nutrients in the culture medium are two of the chief handicaps hindering the production of high density algal culture under controlled conditions. To overcome these problems different culture media were formulated for the maintenance of stock cultures, master cultures and mass production using 2–10 m3 capacity out-door culture tanks (Table 3). The use of sodium bicarbonate instead of CO2 was demonstrated to increase the cell density of phytoplankton cultures within a short period.
The results of the above investigations were as follows:
Investigations on the isolation of unicellular algae from local seawater resulted in isolating the following three species of phytoplankton: Chlorella sp., Thalassiosira sp. and Chaetoceros sp. These have an excellent potential for aquaculture purposes. Thalassiosira sp. has been reported to be a good feed for bivalves of comparable value to Dunaliella sp. and Isochrysis sp. (Epifanio et al. 1975).
The maintenance of auxenic phytoplankton cultures was demonstrated through the practice of isolation and stock culture maintenance procedures.
Modifications in the nutrient media helped to increase considerably the cell density of the phytoplankton cultures. The previous and present cell densities of the phytoplankton cultures were as follows:
| Species | Previous cell density (×106cells m -1) | Present cell density (×106cells m -1) |
| Chlorella virginica | 0.17 | 30 |
| Totraselmis chuii | 0.56 | 1.6 – 3.0 |
The use of nutrients for the culture of diatoms was specified.
Any reduction in the number of different living organisms required to feed the larval stages of a cultured species is a significant improvement. Thus bakers' yeast, as an inert feed, is widely used in aquaculture to cope with inadequate facilities for the culture of other suitable live feeds. In contrast to baker's yeast, marine yeast helps to maintain cultures in good condition, since the yeast cells do not disentegrate in seawater causing water quality problems. The mass culture and utilization of marine yeast has been practiced at the Mariculture and Fisheries Department of the Kuwait Institute for Scientific Research. Since it is an efficient feed for the protozoeal stages of shrimp larvae, it was desirable to culture marine yeast at the Fisheries Research Institute. Although the necessary chemicals and equipment were not available in the Station, the staff of the Research Institute managed to procure most of the required chemicals in time. Of the essential equipment, a micro-fermentor was not available. However, locally available materials were utilized for establishing the marine yeast culture. The regular procedure for marine yeast culture has been given in Appendix I. The staff involved were: Ms. Faazaz Mr. Ali Awang
The results of the investigations were as follows:
The marine yeast (Candida sp., MFD-Y. St. -03) was successfully inoculated and maintained in a pure condition;
An optimum cell density of 400–500 × 106 cells m
-1 was
achieved in the flask cultures;
Marine yeast production of up to 20
using a 30
capacity
fibreglass tank was achieved with up to 360 × 106 cells
m
-1.
The use of marine yeast as feed for zooplankton and shrimp larvae was demonstrated.
5.1 STATUS AND CONSTRAINTS
The culture of rotifers at the Fisheries Research Institute
has been started very recently. The rotifer, Brachionus sp.,
had been isolated from local brackish waters and maintained in
3 m3 capacity fibreglass tanks. The taxonomic identity of the
species has not yet been determined, although it appears to be
similar to B. plicatilis. During this year the culture had been
carried out using 15 m3 tanks for feeding the larvae of Lates
calcarifer. However the production was very low compared to its
volume, due to low rotifer densities (50 individuals m
-1).
Although bakers' yeast and Chlorella had been utilized, the feed
quantities had not been defined. The culture of rotifers was
being hampered by the following biological and technical problems:
Absence of a reliable and proven feed for large-scale production.
The lack of suitable high density algal cultures for mass production.
5.2 MATERIALS AND METHODS
5.2.1 Slant culture
Goto's agar medium (Table 4) was used to prepare the slants. The marine yeast seed stock brought from Kuwait was introduced on to the agar slants and incubated at 30°C for 24 h. These slants were utilized to start the flask culture.
5.2.2 Flask culture
First day: The medium was prepared using the ingredients
given in Table 5. The medium was dispensed into 250 m
capacity
flasks (a few 200 m
and 100 m
flasks were also utilized) and
made up with 50 m
of medium in each flask. The flasks were
covered with cotton plugs and aluminium foil, and autoclaved.
Second day: To each flask was added 0.5 m
of vitamin mix
(Table 5). About 5 ml of sterile seawater was introduced into
each slant in order to make a suspension of the yeast colonies.
This was then *inoculated into the flasks (one slant per flask)
and each was closed with a cotton plug. The flasks were incubated
using a shaker incubator at about 100 rpm at 30°C for 24 h
(Plate VI).
5.2.3 30
cultures
As jar fermentors were not available for scaling up the cultures, a conical fibreglass tank provided with aeration was utilized (Plate VII). Mr. Ali Awang attempted the culture of marine yeast using a synthetic culture medium (Table 6). Flask cultures were used as the inocula.
Insufficient facilities to identify and maintain proper seed stocks for mass production.
Low rotifer culture densities.
5.3 DEMONSTRATION AND ACCOMPLISHMENTS
Staff involved: Mr. Ali Awang
The immediate requirement for the culture of rotifers was the availability of adequate quantities of Chlorella. In addition it was necessary to conduct experiments using different feed combinations. The following feed combinations were tested:
Chlorella with bakers' yeast;
Tetraselmis chuii with bakers' yeast.
In addition, the use of organic fertilizers for the production of rotifers was tested in order to reduce the cost of production, manpower utilization and easy access of transfer of technology to the local fish farmer. The following culture medium was used:
| Cowdung | 500 g |
| Soybean residue or Oil cake | 100 g |
| Urea | 0.5 g |
| Superphosphate | 0.5 g |
| Seawater | 300 ![]() |
During the experimental period, the rotifer cultures were frequently affected by monsoon rains which caused serious fluctuations in salinity (minimum 20‰) as the rotifer culture tanks were not covered. However, the following results were achieved:
The culture density was increased to more than 150 individuals
m
-1.
A feeding schedule for the rotifers was properly defined.
The use of Tetraselmis chuii for routine culture and for the production of amictic rotifers was demonstrated.
6.1 STATUS AND CONSTRAINTS
Artemia culture in a 3 m3 capacity tank had been maintained for experimental cyst production. The production of adult Artemia for biomass had not however been considered necessary for larval feeding. Poultry feed was being utilized for the culture of Artemia. The following constraints were observed:
Lack of knowledge of the decapsulation technique for Artemia cysts;
Inadequacy of tank design and the general facilties for biomass production.
6.2 DEMONSTRATION AND ACCOMPLISHMENT
| Staff involved: | Ms. Puan Choo |
| Mr. Othman Mohammed |
As previous attempts to decapsulate Artemia cysts had not been successful the research staff of the Institute felt it necessary to have a demonstration of the technique. The design and fabrication of experimental culture facilities were also necessary.
The following procedure was followed to decapsulate Artemia cysts:

California strain Artemia cysts were used for decapsulation. Fresh nauplii appeared within 24 h of incubation.
During the consultancy programme the following results were accomplished:
The process of Artemia cyst decapsulation was explained and the technique demonstrated;
Alternative feeds for Artemia biomass production were suggested including unicellular algae such as Tetraselmis sp., inert feeds such as rice bran along with vitamin mix.
Experimental culture systems using air-lift raceways for high density Artemia culture were designed and fabricated in co-ordination with the local staff.
7.1 STATUS AND CONSTRAINTS
No attempts had been made at culturing copepods due to the lack of culture technology and facilities.
7.2 DEMONSTRATION AND ACCOMPLISHMENTS
Field trips were carried out to investigate the possibility
of isolating a local species for mass culture. Plankton samples
from several localities in Penang was collected. The collections
were kept overnight in 20
capacity buckets provided with aeration.
After screening the collections under the microscope, a plankton
collection obtained from the estuarine area near the international
airport was sub-cultured using small beakers and jars. The
salinity was maintained at 15‰. Tetraselmis chuii was at first
utilized for feeding the copepods. After about a week, the
cultures were examined again for desirable species. It was therefore
possible to isolate some species of cyclopoid copepods which
appeared to have a short lifespan. The isolated species were fed
daily with a few drops of cultured marine yeast (candida sp.).
The results of the above investigations are summarized as follows:
The process of collection and isolation of copepods from local waters was demonstrated.
Technical information on the maintenance of experimental copepod cultures was provided.
Acartia sp. and cyclopoid copepods were isolated and
maintained in stock cultures (10
) using brackish water
of 15‰ salinity.
8.1 CULTURE OF UNICELLULAR ALGAE
8.1.1 Isolation and stock culture maintenance
Solid traslucent media such as gels are often of great value or indispensable for plating, for maintaining cultures and for experimental purposes. The principal objective attained by using these media is to attach the algal cells to a flat surface on which they can be easily observed and can develop into genetically homogeneous populations. To keep the cultures in pure condition it is necessary to observe proper isolation and incubation procedures. As demonstrated during the consultancy programme additional facilities should be provided for the isolation and incubation of different species of algae. It is recommended that generally local species should be isolated for mass culture.
At present, facilities for isolation and incubation of different species of unicellular algae are inadequate. It is recommended that a controlled temperature room is established with fluorescent daylight tubes for maintaing stock cultures.
At present applied research is given priority over basic research to meet immediate requirements. To augment this, further studies are required regarding the growth kinetics of the algae which are being used, in relation to light intensity, photoperiod, temperature and micro-nutrients. Chemostats may also be used in future for the continuous production of algae.
As Chaetoceros sp. are dominant and available throughout the year in the local seawater, it may be possible to isolate and mass culture this species within a short period. However, the mass culture of local Thalassiosira sp. (which is not abundantly distributed in the local waters) may also be given priority because of its value as a feed for both shrimp larvae and bivalves.
According to the present culture conditions the following flow chart should be followed for the algal production:

8.2 MARINE YEAST
The immediate requirement for the culture of marine yeast is an inoculation chamber (glove cabinet) to maintain strict anaerobiosis and also a well-equiped fermentation unit. In modern fermentation technology, there are several important objectives. One major concern is the definition of optimum environmental conditions that will maximise cellular activity and enhance product yield. Another objective is the translation of these results from the fermentation pilot plant to the production plant.
In searching for solutions to these problems, there are generally two types of facilities which can be used:
Those with a large number of simple pilot-scale culture vessels. Environmental conditions are varied in each individual fermentor and the results are then compared at the end of fermentation.
Those with a small number of highly complex electronically controlled-environment fermentors which are interfaced with a micro-processor. In this case, the micro-processor has the capability of acquiring the process information and analysing it as the trials proceed in order to obtain insight into changes in the physicochemical nature of the culture medium as well as the physico-chemical nature of the organisms and biochemical activity related to primary and secondary metabolite production.
As a result of the experience obtained over the past few years, micro-processor controlled fermentation is beginning to replace the old ‘classical’ method of fermentation research and development. To scale up the cultures from flasks to fermentors, the automated Microferm fermentor from New Brunswick Scientific Co., Inc. (Appendix II) may be very useful.
According to the present requirements it may be sufficient
to produce up to 50
d-1 of marine yeast. However, in future
the marine yeast culture can be scaled up to 600
capacity. The
production tanks may be fabricated locally according to the
specifications and tank design shown in Fig. 1.
8.3 ROTIFERS
To establish a stable rotifer production system, it is essential to start the culture using rejuvenated amictic rotifers. During the consultancy period the maintenance of such seed stock cultures was demonstrated. However it was not possible to conduct a full scale demonstration of the rotifer production system due to the following reasons:
Non-availability of large quantities (1–2 m3 d-1) of algae
having a high cell density (minimum 20 × 106 cells m
-1
for Chlorella). This was mainly due to the climatic conditions
as a result of which heavy monsoon rains altered the
environmental conditions.
Lack of facilities for setting up the tanks under controlled conditions (greenhouse).
The short period of the consultancy programme during which attention had to be focussed mostly on establishing stable culture conditions for algae which are essential for feeding the zooplankton and other filter feeders.
During the consultancy period although considerable improvement in the techniques for the mass culture of rotifers were established, further improvements in the culture system may be achieved by using the following culture procedure:
Schedule for 10 m' capacity rotfier culture
| Day | Morning | Noon | Evening/Night | Expected rotifer density no. m -1 |
| 1 | 500 Chlorella* | 15 Marine** yeast | 50g Bakers' yeast | 50 |
| + | ||||
| 2 m3 brackish water (30‰) | ||||
| + | ||||
| Rotifer seed | ||||
| 2 | 500 Chlorella | 30 Marine yeast | 50g Bakers' yeast | > 50 |
| + | ||||
| 2 m3 brackish water (30‰) | ||||
| + | ||||
| 50g bakers' yeast | ||||
| 3 | 500 Chlorella | 30 Marine yeast | 50g Bakers' yeast | > 100 |
| + | ||||
| 2 m3 brackish water | ||||
| + | ||||
| 50g bakers' yeast | ||||
| 4 | 500 Chlorella | 30 Marine yeast | 150g Bakers' yeast | > 150 |
| + | ||||
| 2 m3 brackish water | ||||
| + | ||||
| 50g bakers' yeast | ||||
| 5 | 500 Chlorella | 30 Marine yeast | 150g Bakers' yeast | > 250 |
| + | ||||
| 100g bakers' yeast | ||||
| 6 | 500 Chlorella | 30 Marine yeast | 150g Bakers' yeast | > 400 |
| + | ||||
| 150g bakers' yeast |
* Using Chlorella with 20 × 106 cells m
-1 cell density.
** 15
yeast (10g
-1 dry weight) diluted with 15
seawater andallowed to drip for 12 hours.
While using the above procedure thinning or harvest may be carried out as per requirements. However, to keep the cultures continuously for more than 3 weeks, it is necessary to thin the rotifers and add new brackish water (30‰) as per the culture conditions.
8.4 ARTEMIA AND COPEPODS
The facilities available at present are adequate. However,
the use of 500
capacity fibreglass thanks will be beneficial
for experimental studies and for the culture of copepods.
It is essential that standard formats for data collection and reporting are followed. This helps in the statistical analysis of the observations and in the scientific interpretation of the results. Examples of data sheets which may be useful in maintaining a record of the culture procedures are included in Appendix IV.
After developing techniques and facilities for live food production, it is very important to analyse the nutritional quality of the product. This requires a biochemical analysis of the feeds. Depending on the results, the dietary value of a particular feed may be enhanced by providing proper culture conditions. The investigations of Arakawa et al. (1979); Kitajima, et al. (1980a, b); Oka et al. (1980) and Watanabe et al. (1981) clearly show that the dietary value of rotifers for fish larvae can be significantly improved by using a combination of ω-yeast and Chlorella rather than Chlorella alone.
During the present consulting programme live food production techniques only were demonstrated. However, further investigations will probably be necessary to enhance the nutritional quality of the feeds produced.
Arakawa, T., Yogata, T. and Watanabe, T., 1979. Rearing of larvae of puffer (Fugurubripes rubripes) by rotifer (Brachionus plicatilis) cultured with various feeds. Bulletin of the Nagasaki Prefecture Institute of Fisheries, 5: 5–8.
Epifanio, C.E., Logan, C.M. and C. Turk, 1975. Culture of six species of bivalves in a recirculating seawater system. Proc. 10th European Symposium on Marine Biology, Ostend, Beglium, Sept. 17–23, 1: 97–108.
Kitajima, C., Arakawa, T., Fujita, S., Imada, O., Watanabe, T. and Yone, Y., 1980a. Dietary value for red sea bream larvae of rotifer Brachionus plicatilis cultured with a new type of yeast. Bulletin of the Japenese Society of Scientific Fisheries, 46: 43–46.
Kitajima, C., Yoshida, M. and Watanabe, T., 1980b. Dietary value for Ayu Plecoglossus altivelis of rotifer Brachionus plicatilis cultured with baker's yeast Saccharomyces cerevesiae supplemented with cuttlefish liver oil. Bulletin of the Japanese Society of Scientific Fisheries, 46: 47–50.
Oka, A., Suzuki, N., and Watanabe, T., 1980. Effect of fatty acids in rotifers on growth and fatty acid composition of larval Ayu Plecoglossus altivelis. Bulletin of the Japanese Society of Scientific Fisheries, 46: 1413–1418.
FUTURE READING
Litchfield, J.H., 1977. Use of hydrocarbon fractions for the production of SCP. Biotechnology and Bioengineering Symposium proceedings, 7: 77.
Poppler, H.J., 1979. Production of yeast and yeast products, in Microbial Technology, 2nd ed., Academic Press, New York, Vol. 1, Chapter 5.
Rose, A.H., 1979. Economic microbiology. Vol. 4. 439 pp. Academic Press Inc. London.
Reed, G. and Poppler, H.J., 1973. Yeast Technology, AVI, Westport, Connectieut. 150 pp.
White, J., 1948. The principle and practice of yeast production, Part I. American Brewer, July 1948, p. 21.
| Ingredients | Quantity | |
| Solution ‘A’ | KNO3 | 20.2 g |
| Distilled water | 100 m![]() | |
| Solution ‘B’ | Na2HPO4. 12H2O | 4.0 g |
| CaCl2. 4H2O | 4.0 g | |
| HCl | 2.0 m![]() | |
| FeCl3 | 2.0 g | |
| Distilled water | 100 m![]() | |
Procedure: Add 0.55 m of solution ‘A’ and 0.5 m of solution ‘B’ to 1 of water. | ||
| Ingredients | Quantity |
| Na No3 | 100.0 g -1 |
| Na2 EDTA | 45.0 g -1 |
| H3BO3 | 33.4 g -1 |
| Na H2 PO4.2H2O | 20.0 g -1 |
| Fe Cl3.6H2O | 1.3 g -1 |
| MnCl2.4H2O | 0.36 g -1 |
| *Trace metal solution | 1.0 m -1 |
| **Vitamins | 0.1 m -1 |
* Prepared from:
Zncl2 2.1 g
-1
CaCl2. 6H2O 2.0 g
-1
(NH4) 6MO7O24.4H2O 0.8 g
-1
** Prepared from:
Vitamin B12 10 mg
Vitamin B1 200 mg
Dissolved to make 200 m
solution.
| Culture medium for Chlorella (m-3) | Culture medium for Tetraselmis sp. (m-3) | Culture medium for diatoms (m-3) | |||
| Ingredients | Quantity | Ingredients | Quantity | Ingredients | Quantity |
| Urea | 10.0 g | Urea | 10.0 g | Ca (H2PO4) | 10.0 g |
| Ca (H2PO4) | 5.0 g | KNO3 | 6.25g | KNO3 | 5.0 g |
| KNO3 | 5.0 g | Ca (H2PO4) | 6.25g | Fe Cl3 | 2.5 g |
| Clewat-32* | 3.0 g | MgSO4.7H2O | 6.25g | Na2SiO3 | 1.25g |
| FeSO4.7H2O | 2.5 g | Clewat-32* | 2.5 g | ||
| Clewat-32* | 2.5 g | ||||
* Commercial product of Fisheries and Aquaculture Inc. Co., Japan, which is used instead of EDTA.
| Ingredients | Quantity |
| Polypeptone | 10.0 g |
| Yeast extract | 5.0 g |
| Glucose | 20.0 g |
| Agar | 15.0 g |
| Seawater | 1 ![]() |
| Flask culture | Fermentor | |
| Ingredients | Quantity | Quantity |
| Glucose | 50 g | 50 g |
| Urea | 2 g | 2 g |
| KH2PO4 | 1 g | 1 g |
| Na2 H PO4 | 1 g | 1 g |
| *Vitamin mix | 10 m![]() | 10 m![]() |
| Molasses | - | 3 m![]() |
| Sodium hypochlorite | - | 1 m![]() |
| **Fish oil | - | 3 m![]() |
| **Tween-80 | - | 1 m![]() |
| Brackish water (30‰) | 1 ![]() | 1 ![]() |
** Used only for the production of ω-marine yeast.
| *Ingredients | Quantity ( -1) |
| Inositol | 12 g |
| Thiamine hydrochloride (vitamin B1) | 240 mg |
| Riboflavin (vitamin B2) | 120 mg |
| Pyridin hydrochloride | 240 mg |
| Nicotinic acid | 240 mg |
| P. amino-benzoic acid | 120 mg |
| Co-pantothenate | 120 mg |
| Biotin | 1 m (of a stock solution: 500 mg -1) |
| Deionized water | 1 ![]() |
Table 6. Composition of synthetic medium for 20
cultures (pH adjusted to 4 using 20%
hydrochloric acid).
| Ingredients | Quantity |
| Glucose | 10 g |
| Ammonium sulphate | 1 g |
| Potassium phosphate | 0.1 g |
| Seawater | 1 ![]() |

Fig. 1. Mass culture tanks for the production of the marine yeast Candida sp.: A. 50 l capacity fermentor; B. 600 l capacity fermentor. a, Motor with 1 HP; b, Paddles for agitation and mixing; c, Ring mains for aeration; d, Paddles for mixing and e, Outer chamber for seawater circulation for cooling.

Plate I. Incubation unit fabricated locally for use in isolation procedures and to maintain the stock culture.

Plate II. Inoculation of pure algal colonies in tubes with different culture media for evaluation of different nutrient media.

Plate III. Slant cultures and tube cultures of local Chlorella sp. and Chaetoceros sp.

Plate IV. Process of isolation of pure colonies from agar plates.
Plate V. Agar plates with developing algal colonies during the process of isolation.

Plate VI. Shaker-incubator used for the flask culture of marine yeast.

Plate VII. Conical fibreglass tanks utilized for the culture of marine yeast.

Plate VIII. 20
marine yeast culture in the fibreglass
tank with 360 × 106 cells m
-1.
Slant culture: Goto's agar medium should be used for the preparation of slants. Slants are first inoculated and then incubated at 30°C for 24 h. These slants are utilized to start the flask culture.
Flask culture (To prepare 10 flasks with 50 m
/flask):
| Ingredients: | 25 g sugar; |
| 1 g urea; | |
| 0.5 g Na2HPO4; | |
| 0.5 g KH2PO4; | |
500 m brackish water. (The salinity should be maintained at 30‰). |
First Day
Dissolve and mix the ingredients in the water. Dispense the
medium into 250 m
capacity flasks (if 250 m
flasks not available
use 200 or 100 m
flasks) at the rate of 50 m
of medium per flask.
Close and flasks with cotton plugs and aluminium foil.
* Prepare some tubes with freshwater (20 m
), 30 m
of fish oil
(in a small flask) and 10 m
of Tween-80 (in a test tube).
Autoclave all the above containers for 30 min.
Second Day
Take the flasks containing the sterile synthetic medium to
the inoculation chamber and then add 0.5 m
of vitamin mix to each
flask. (The vitamin mix should be prepared in advance and kept
in a stock solution.) Add 5 m
of sterile water to each slant
and stir the yeast colonies on the gel to make a suspension. Pour
the suspension from the tube into a flask (one tube per flask) and
close it with a cotton plug.** Incubate the flasks in a shaker
incubator at 100 rpm at 30°C for 24 h.
* Required for the production of ω-marine yeast only.
** All the above steps should be carried out inside an inoculation
chamber beside an alcohol lamp.
3. Jar Fermentor Culture (10
× 2 capacity)
| Ingredients: | 500 g sugar; |
| 20 g urea; | |
| 10 g KH2PO4; | |
| 10 g Na2HPO4; | |
10 brackish water (30‰ salinity); | |
30 m molasses; | |
10 m vitamin mix; | |
10 m NaOCl; | |
(30 m Fish Oil; 10 m Tween-80);*** | |
| Maintain pH at 4.5 using 20% hydrochloric acid. |
*** Required for the production of ω-marine yeast only.
Procedure:
Prepare the medium and pour into the 10
jar. Adjust
the controls so as to maintain the temperature at 30°C and
pH at 4.5. Wait for 30 min till the ingredients are mixed
well in the container. Then inoculate it with yeast from one
of the flask cultures. An antifoaming agent should be provided
in the unit. Ferment for 24 h.
4. 50
cultures:
Prepare synthetic medium (40
) according to Table 5.
Inoculate with 10
of marine yeast culture. Ferment for 24 h.
5. 600
cultures:
Prepare 550
of synthetic medium according to Table 5.
Inoculate with 50
of marine yeast. Ferment for 24 h.
Growth studies:
To study the growth of marine yeast the following procedure should be adopted.
Dilute l m
of marine yeast culture 25 times.
Use a spectrophotometer with a wave length of 560mm.
Convert the spectrophotometer readings to real values using a calibration table.
Table value × 25 (i.e. dilution factor) × 1.2 = g
-1
dry weight of marine yeast.
| A. Chemicals | Supplier |
| Tween-80 (Polyoxyethylene (20) Sorbitan Mono-oleate). | Riedel De Haan Ag., West Germany. |
| BDH Chemical Ltd., England. | |
| Polypeptone or Bacto-peptone | Difco Laboratories, Detroit, Michigan, U.S.A. |
| Yeast Extract-Technical | Difco Laboratories, Detroit, Michigan, U.S.A. |
| Clewat-32 | Fisheries and Aquaculture Inc. Co., Maeda Building No. 205, 3–15–13 Minami Ikebukuro, Toshima-ku, Tokyo-171, Japan. |
| Omega Feed Oil | Fisheries and Aquaculture Inc. Co., Maeda Building No. 205, 3–15–13 Minami Ikabukuro, Toshima-ku, Tokyo-171, Japan. |
| B. Equipment | |
Microferm Fermentor with pH controller (available in different capacities, 5 or 10 capacity may be sufficient). | New Brunswick Scientific Co., Inc., 1130 Somerset St., New Brunswick, New Jersey 08903, U.S.A. |
| Psycrotherm - The controlled Environment Incubator Shaker. | New Brunswick Scientific Co., Inc., 1130 Somerset St., New Brunswick, New Jersey 08903, U.S.A. |
| Glove cabinet | Forma Scientific Division of Mallinckrodt, Inc., Box 649, Marietta, Ohio 45750, U.S.A. |
ROTIFER CULTURE
Tank No:
| Day | Date | Salinity ‰ | pH | Temperature °C | D O mg -1 | Type and feed quantity | Density (m -1) | Harvest/thinning | Final number(m -1) | Remarks | |||
| Eggs | Rotifers | Volume (m3) | Number (x106) | Eggs | Rotifers | ||||||||
Observations:
MASS CULTURE OF Artemia salina
Tank No:
| Day | Date | Salinity ‰ | pH | Temperature °C | D O mg -1 | Type and feed quantity | Population Data | Quantity harvested/ Remarks | ||||
| Date | Stage | Length (mm) | Range, mean, s.d. | No. -1 | ||||||||
Observations :
| Species: | COPEPOD CULTURE | Tank No: |
| Day | Date | Salinity ‰ | pH | Temperature °C | D O mg -1 |
Type and feed quantity | Population Data | Quantity harvested/remarks. | ||||
Egg clutch No. -1 | Nauplii No. -1 | Copepodites No. -1 | Copepods No. -1 | Total No. -1 | ||||||||
Observations: